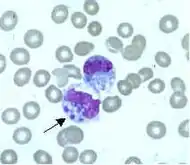

Фагоциты

Фагоци́ты (от др.-греч. φαγεῖν «пожирать» + κύτος «клетка»[1]) — клетки иммунной системы, которые защищают организм путём поглощения (фагоцитоза) вредных чужеродных частиц (бактерий, вирусов), а также мёртвых или погибающих клеток[2]. Они важны для борьбы с инфекцией и постинфекционного иммунитета[3]. Фагоцитоз важен для всего животного мира[4] и высоко развит у позвоночных[5]. Роль фагоцитов в защите от бактерий была впервые открыта И. И. Мечниковым в 1882 году, когда он изучал личинок морских звёзд[6]. Мечников был удостоен в 1908 году Нобелевской премии по физиологии за создание клеточной теории иммунитета[7]. Фагоциты присутствуют в организмах многих видов; некоторые амёбы по многим деталям поведения похожи на макрофаги, что указывает на то, что фагоциты появились на ранних этапах эволюции[8].
Фагоциты человека и других животных называют «профессиональными» или «непрофессиональными» в зависимости от того, насколько эффективно они фагоцитируют[9]. К профессиональным фагоцитам относятся нейтрофилы, моноциты, макрофаги, дендритные клетки и тучные клетки[10][11]. Основное отличие профессиональных фагоцитов от непрофессиональных заключается в том, что профессиональные имеют на своей поверхности молекулы, называемые рецепторами, которые обнаруживают чужеродные объекты — например, бактерии[12]. Один литр крови взрослого человека в норме содержит около 2,5—7,5 млрд нейтрофилов, 200—900 млн моноцитов[13].
При инфекции химические сигналы привлекают фагоциты к месту, где патоген проник в организм. Эти сигналы могут исходить от бактерий или от других фагоцитов, уже присутствующих там. Фагоциты перемещаются путём хемотаксиса. При контакте фагоцита с бактерией рецепторы на его поверхности связываются с ней, что ведёт к поглощению бактерии фагоцитом[14]. Некоторые фагоциты убивают проникших патогенов с помощью активных форм кислорода и оксида азота[15]. После фагоцитоза макрофаги и дендритные клетки могут также участвовать в презентации антигена — процессе, при котором фагоциты перемещают патогенный материал обратно на свою поверхность. Этот материал затем представляется (презентируется) для других клеток иммунной системы. Некоторые фагоциты поступают в лимфатические узлы и презентируют материал лимфоцитам. Данный процесс играет важную роль в формировании иммунитета[16]. Тем не менее многие болезнетворные микроорганизмы устойчивы к атакам фагоцитов[3].
История открытия

Хотя явление, позже названное фагоцитозом, впервые наблюдали американский врач Джозеф Ричардсон в 1869 году и канадский врач Уильям Ослер в 1875 году, их работы не вызвали заметного интереса у современников[17][18]. Именно русский биолог Илья Ильич Мечников впервые убедительно показал, что специализированные клетки участвуют в защите от микробной инфекции. В первых своих исследованиях он наблюдал поглощение такими клетками чужеродного материала в ходе экспериментов с ресничными червями (1878) и стрекающими (1880)[19]. В 1882 году он изучал подвижные клетки в личинках морских звёзд и предположил, что они важны для иммунной защиты животных. Чтобы проверить эту мысль, он воткнул небольшие иголки от мандаринового дерева в личинку и через несколько часов обнаружил, что подвижные клетки окружили иголки[20]. Мечников отправился в Вену и поделился своей идеей с Карлом Клаусом; тот предложил для клеток, которые наблюдал Мечников, название «фагоциты»[21].
Год спустя Мечников изучал пресноводное ракообразное — дафнию, маленькое прозрачное животное, которое можно изучать непосредственно под микроскопом. Он обнаружил, что грибные споры, которые попадали на дафний, уничтожались фагоцитами. Мечников продолжил свои наблюдения на белых кровяных клетках млекопитающих и обнаружил, что Bacillus anthracis также может быть уничтожена фагоцитами. Процесс захвата и переваривания бактерий и других объектов фагоцитами он назвал фагоцитозом[22]. Мечников предположил, что фагоциты — первичная защита от проникающих микроорганизмов. Мечников был награждён (вместе с Паулем Эрлихом) в 1908 году Нобелевской премией по физиологии или медицине за свою работу по фагоцитам и фагоцитозу[7]. В 1903 году Алмрот Райт обнаружил, что фагоцитоз поддерживается специфическими антителами, которые он назвал опсонинами[23].
Хотя значение этих открытий постепенно получило признание в начале двадцатого века, сложный характер взаимоотношений между фагоцитами и другими компонентами иммунной системы не был известен вплоть до 1980-х годов[24].
Фагоцитоз

1. Несвязанные рецепторы на поверхности фагоцита не запускают фагоцитоз.
2. Связывание рецепторов вызывает их группирование.
3. Запускается фагоцитоз и частица поглощается фагоцитом
Фагоцитоз — процесс поглощения чужеродных частиц клетками[25]. Он включает последовательность молекулярных процессов[26]. Фагоцитоз возникает после связывания рецепторами чужеродного агента (например, бактерии). Затем фагоцит окружает бактерию и поглощает её. Фагоцитоз бактерии человеческим нейтрофилом происходит примерно за 9 минут[27]. Внутри фагоцита бактерия оказывается в составе фагосомы. В течение минуты фагосома сливается с лизосомой или гранулой, содержащими ферменты, с образованием фаголизосомы. Заключённая бактерия подвергается агрессивному воздействию[28] и погибает через несколько минут[27]. Дендритные клетки и макрофаги действуют не так быстро, и фагоцитоз в этих клетках может протекать в течение многих часов. Макрофаги поглощают большое количество чужеродного материала и часто выделяют некоторые непереваренные частицы обратно. Этот материал является сигналом для миграции макрофагов из крови[29]. Фагоциты способны поглощать почти любое вещество.

Фагоциты имеют на своей поверхности множество различных рецепторов, благодаря которым они связывают чужеродный материал[3]. К ним относятся опсониновые рецепторы, скевенджер-рецепторы и Toll-подобные рецепторы. Опсониновые рецепторы усиливают фагоцитоз бактерий, которые покрыты иммуноглобулином G (IgG) или комплементом. Комплемент — комплекс белковых молекул в крови, которые разрушают клетки или помечают их для уничтожения[30]. Скевенджер-рецепторы связываются с разнообразными молекулами на поверхности бактериальной клетки, и Toll-подобные рецепторы связываются с более специфичными молекулами. Связывание Толл-подобных рецепторов усиливает фагоцитоз и вызывает выброс фагоцитами группы факторов, которые вызывают воспаление[3].
Механизмы уничтожения чужеродных агентов

Уничтожение микроорганизмов — важная функция фагоцитоза[31], которая происходит либо при фагоцитозе (внутриклеточное уничтожение), либо вне фагоцита (внеклеточное уничтожение).
Внутриклеточный кислород-зависимый путь
Когда фагоцит поглощает бактерию (или любой другой чужеродный материал), увеличивается потребление кислорода, что называют респираторным взрывом. При этом образуются активные формы кислорода, которые обладают противомикробным действием[32]. Соединения кислорода токсичны как для патогена, так и для самой клетки, поэтому они хранятся в ячейках внутри самой клетки. Такой метод уничтожения проникающих микроорганизмов называют кислород-зависимое внутриклеточное уничтожение, который делится на два типа[15].
Первый тип — кислород-зависимое образование супероксидного радикала[3], уничтожающего бактерии[33]. Супероксид превращается в пероксид водорода и синглетный кислород под действием фермента супероксиддисмутазы. Супероксиды также взаимодействуют с пероксидом водорода с образованием гидроксильной группы, которая помогает в уничтожении патогенных микробов[3].
Ко второму типу относят использование фермента миелопероксидаза из нейтрофильных гранул[34]. Когда гранулы сливаются с фагосомой, миелопероксидаза освобождается в фаголизосому, и этот фермент использует пероксид водорода и хлор для создания гипохлорита. Гипохлорит крайне токсичен для бактерий[3]. Миелопероксидаза содержит пигмент гем, за счёт которого образуется зелёный цвет секретов, богатых нейтрофилами (например, гной, инфицированная мокрота)[35].
Внутриклеточный кислород-независимый путь

Фагоциты также могут уничтожать микроорганизмы кислород-независимым методом, но он менее эффективен, чем кислород-зависимый. Различают четыре основных типа. При первом типе используются заряженные белки, которые повреждают клеточную мембрану бактерий. При втором типе используются лизосомные ферменты, которые разрушают клеточную стенку бактерий. При третьем типе используются лактоферрины, которые присутствуют в гранулах нейтрофилов и удаляют необходимое железо из бактерий[36]. При четвёртом типе используются протеазы и гидролазы для переваривания белков разрушенных бактерий[37].
Внеклеточные пути
Интерферон-гамма (который также называют фактором, активирующим макрофаги) активирует синтез макрофагами оксида азота. Источником интерферона-гамма могут быть CD4+ T-лимфоциты (T-хелперы), CD8+ T-лимфоциты (T-киллеры), естественные киллеры, B-лимфоциты, моноциты, макрофаги или дендритные клетки[38]. Оксид азота затем высвобождается из макрофагов и, в силу своей токсичности, уничтожает микробы вблизи макрофага[3]. Активированные макрофаги образуют и секретируют фактор некроза опухоли. Этот цитокин (класс сигнальных молекул)[39] уничтожает раковые клетки и клетки, инфицированные вирусом, помогают активировать другие клетки иммунной системы[40].
При некоторых заболеваниях, например, при редких хронических гранулёматозных заболеваниях, эффективность фагоцитоза нарушается, что может привести к возникновению бактериальных инфекций[41]. При таких заболеваниях существует аномалия в работе различных элементов кислород-зависимого уничтожения микробов. Другие редкие врождённые аномалии, например синдром Шедьяка — Штайнбринка — Хигаси, также связаны с дефектным уничтожением проникающих в организм микробов[42].
Вирусы
Вирусы могут воспроизводиться только внутри клетки, и они проникают в неё, используя множество рецепторов, участвующих в иммунной защите. Попав внутрь клетки, вирусы используют её биологические процессы в свою пользу, заставляя клетку создавать тысячи вирусных частиц, подобных материнской. Хотя фагоциты и другие компоненты иммунной системы могут в ограниченной степени контролировать вирусы, когда вирус внутри клетки, приобретённый иммунитет (в частности, лимфоциты) более важен для защиты[43]. В области вирусной инфекции лимфоцитов скапливается гораздо больше, чем остальных клеток иммунной системы, что наиболее типично для вирусного менингита[44]. Клетки, инфицированные вирусами, уничтожаются лимфоцитами и выводятся из организма фагоцитами[45].
Роль в апоптозе

У животных, растений и грибов клетки постоянно погибают. Баланс между делением клетки и их гибелью сохраняет относительно постоянное число клеток у взрослых[2]. Существует два механизма гибели клетки: некроз и апоптоз. В отличие от некроза, который чаще возникает как результат заболевания или травмы, апоптоз (или запрограммированная гибель клеток) — нормальный процесс, постоянно протекающий в организме. Организм избавляет себя от миллионов мёртвых или погибающих клеток каждый день, и фагоциты играют важную роль в этом процессе[46].
Погибающая клетка, которая подвергается финальной стадии апоптоза[47], экспонирует некоторые специфические молекулы (например, фосфатидилсерин) на своей поверхности для соединения с фагоцитом[48]. Фосфатидилсерин обычно находится на цитозольной поверхности плазматической мембраны, но перемещается при апоптозе на внешнюю поверхность предположительно с помощью белка под названием скрамблаза[49]. Эти молекулы помечают клетку для фагоцитоза клетками, которые обладают соответствующими рецепторами, например макрофаги[50]. Удаление погибающих клеток фагоцитами происходит упорядоченным образом, не вызывая воспаления[51].
Взаимодействие с другими клетками
Фагоциты движутся в организме, взаимодействуя с фагоцитарными и нефагоцитарными клетками иммунной системы. Они обмениваются информацией с другими клетками с помощью образования химических веществ, называемых цитокинами, которые вызывают другие фагоциты к области инфекции или активируют «спящие» лимфоциты[52]. Фагоциты составляют часть врождённого иммунитета, который имеется у животных, включая человека, с рождения. Врождённый иммунитет очень эффективен, но не специфичен в отношении определения разницы между видами патогенов. С другой стороны, приобретённый иммунитет более специализирован и может защищать почти от любого вида патогена[53]. Приобретённый иммунитет зависит от лимфоцитов, которые не фагоцитируют, но образуют защитные белки (антитела), которые помечают патогены для уничтожения и предупреждают инфицирование клеток вирусами[54]. Фагоциты, в частности дендритные клетки и макрофаги, стимулируют лимфоциты для образования антител при важном процессе, называемом презентация антигена[55].
Презентация антигена

Презентация антигена — процесс, при котором некоторые фагоциты перемещают части поглощённого материала назад на свою поверхность и «предоставляют» их для других клеток иммунной системы[56]. Существуют 2 вида «профессиональных» антигенпрезентирующих клеток: макрофаги и дендритные клетки[57]. После поглощения чужеродные белки (антигены) разрушаются до пептидов внутри дендритной клетки или макрофага. Эти пептиды затем связываются с гликопротеинами главного комплекса гистосовместимости (MHC) клетки, которые осуществляют возвращение назад на поверхность фагоцита, где они могут быть «представлены» лимфоцитам[16]. Старые макрофаги не способны быстро перемещаться из области инфицирования, но дендритные клетки могут достигать лимфатических узлов организма, где находятся миллионы лимфоцитов[58]. Это способствует развитию иммунного ответа, потому что лимфоциты реагируют на антигены, презентированные дендритными клетками, так же, как если бы они находились в первичной области инфекции[59]. Но дендритные клетки также способны разрушать или подавлять активность лимфоцитов, если они распознают компоненты тела хозяина; это важно для предупреждения аутоиммунных реакций. Этот процесс называют толерантностью[60].
Иммунологическая толерантность
Дендритные клетки также способствуют иммунологической толерантности[61], при которой предупреждается иммунологическая атака организмом самого себя. Первый тип толерантности — центральная толерантность. Она заключается в том, что, когда созревшие T-лимфоциты (Т-клетки) впервые выходят из тимуса, дендритные клетки разрушают дефектные Т-лимфоциты, которые несут антигены, способные вызвать аутоиммунную реакцию. Второй тип иммунологической толерантности — периферическая толерантность. Некоторым аутореактивным Т-клеткам удаётся покинуть тимус по ряду причин — например, из-за того, что в тимусе они не экспрессировали аутоантигены. Другие Т-клетки, известные как регуляторные Т-клетки, подавляют аутоактивные Т-клетки на периферии[62]. Когда иммунологическая толерантность не срабатывает, могут возникнуть аутоиммунные заболевания[63]. С другой стороны, повышенная толерантность может привести к возникновению инфекций (например, ВИЧ-инфекции)[62].
Профессиональные фагоциты

Фагоциты человека и других позвоночных разделяют на «профессиональные» и «непрофессиональные» группы на основе эффективности, при которой они участвуют в фагоцитозе[9]. К профессиональным фагоцитам относят моноциты, макрофаги, нейтрофилы, тканевые дендритные клетки и тучные клетки[10].
| Основное расположение | Варианты фенотипов |
|---|---|
| Кровь | нейтрофилы, моноциты |
| Костный мозг | макрофаги, моноциты, синусоидальные клетки, обкладочные клетки |
| Костная ткань | остеокласты |
| Кишечник и кишечные Пейеровы бляшки | макрофаги |
| Соединительная ткань | Гистиоциты, макрофаги, моноциты, дендритные клетки |
| Печень | клетки Купфера, моноциты |
| Лёгкие | самовоспроизводящиеся макрофаги, моноциты, тучные клетки, дендритные клетки |
| Лимфатическая ткань | свободные и фиксированные макрофаги и моноциты, дендритные клетки |
| Нервная ткань | клетки микроглии (CD4+) |
| Селезёнка | свободные и фиксированные макрофаги, моноциты, синусоидные клетки |
| Тимус | свободные и фиксированные макрофаги и моноциты |
| Кожа | постоянные клетки Лангерганса, другие дендритные клетки, макрофаги, тучные клетки |
Активация
Все фагоциты, особенно макрофаги, находятся в состоянии готовности. Макрофаги, как правило, относительно пассивны в тканях и размножаются медленно. В таком состоянии полупокоя они очищают организм от мёртвых клеток и другого неинфекционного мусора и редко принимают участие в презентации антигена. Но при возникновении инфекции они получают химические сигналы (обычно интерферон гамма), которые увеличивают продукцию ими молекул MHC II и подготавливают их к презентации антигена. В таком состоянии макрофаги — хорошие антиген-презентаторы и киллеры. Однако если они получают сигнал прямо от патогена, они становятся «гиперактивными», прекращают размножение и концентрируются на уничтожении. Их размер и скорость фагоцитоза увеличивается; некоторые становятся достаточно крупными, чтобы поглотить проникающих в организм простейших[65].
В крови нейтрофилы неактивны, но движутся по ней с большой скоростью. Когда они получают сигналы от макрофагов из зоны воспаления, они замедляются и выходят из крови. В тканях они активируются цитокинами и поступают в зону действия готовыми уничтожать[66].
Миграция

Когда происходит инфекционное заражение, выделяется химический «SOS»-сигнал для привлечения фагоцитов в зону инфекции[67]. Эти химические сигналы могут включать белки от поступающих бактерий, системы свёртывания пептидов, продукты системы комплемента, а также цитокины, которые выделяются макрофагами, расположенными в ткани в области инфекции[3]. Другая группа химических аттрактантов — цитокины, которые вызывают нейтрофилы и моноциты из кровеносного русла.[14].
Для достижения зоны инфекции фагоциты выходят из кровеносного русла и проникают в поражённую ткань. Сигналы от инфекции вызывают синтез эндотелиальными клетками, выстилающие кровеносный сосуд, белка, называемого селектин, который сцепляется с проходящими нейтрофилами. Вазодилататоры ослабляют соединительные связи эндотелиальных клеток, что позволяет фагоцитами проходить через стенку сосуда. Хемотаксис — процесс, при котором фагоциты следуют на «запах» цитокинов к области инфекции[3]. Нейтрофилы проникают через органы, покрытые эпителиальной тканью, в зону инфекции, и, хотя это важный компонент борьбы с инфекцией, миграция сама по себе может привести к возникновению симптомов заболевания[68]. При инфекции миллионы нейтрофилов вызываются из крови, но они погибают затем в течение нескольких дней[69].
Моноциты
Моноциты развиваются в костном мозге и достигают зрелости в крови. Зрелые моноциты имеют крупное, гладкое, дольчатое ядро и цитоплазму, которая содержит гранулы. Моноциты поглощают чужеродные или опасные вещества и презентируют антигены другим клеткам иммунной системы. Моноциты образуют 2 группы: циркулирующая и краевая, которые остаются в других тканях (около 70 % находятся в краевой группе). Большинство моноцитов покидают кровеносное русло через 20—40 часов, попадая в ткани и органы, где они превращаются в макрофаги[70] или дендритные клетки в зависимости от получаемого сигнала[71]. В 1 литре крови человека находится около 500 миллионов моноцитов[13].
Макрофаги
Зрелые макрофаги не перемещаются далеко, но стоят на страже в тех областях организма, которые подвержены воздействию внешней среды. Там они действуют как сборщики мусора. Антигенпрезентирующие клетки или естественные киллеры, в зависимости от получаемого сигнала[72]. Они образуются из моноцитов, стволовых клеток, гранулоцитов или при клеточном делении уже существующих макрофагов[73]. Макрофаги человека достигают в диаметре около 21 микрометра[74].

Этот вид фагоцитов не имеет гранул, но содержит много лизосом. Макрофаги находятся по всему телу почти во всех тканях и органах (например, клетки микроглии в головном мозге и альвеолярные макрофаги в лёгких). Расположение макрофага можно определить по его размеру и внешнему виду. Макрофаги вызывают воспаление путём образования интерлейкина 1, интерлейкина 6 и фактора некроза опухоли[75]. Макрофаги обычно находятся только в тканях и редко попадают в кровоток. Продолжительность жизни тканевых макрофагов, по разным оценкам, составляет от 4 до 5 дней[76].После этого они умирают, и другие макрофаги их съедают.В отличие от нейтрофилов макрофаги гной не образуют
Макрофаги могут быть активированы для выполнения функций, которые покоящийся моноцит не может осуществлять[75]. Т-хелперы — подгруппа лимфоцитов, отвечающих за активацию макрофагов. Они активируют макрофаги, посылая сигнал в виде интерферона гамма и экспрессируя белок CD154[77]. Другие сигналы поступают от бактерий в виде фактора некроза опухоли альфа и липополисахаридов[75]. Т-хелперы способны привлекать другие фагоциты в зону инфекции несколькими путями. Они выделяют цитокины, которые действуют на костный мозг, стимулируя образование моноцитов и нейтрофилов, а также выделяют некоторые цитокины, которые отвечают за миграцию моноцитов и нейтрофилов в кровяное русло[78]. Т-хелперы появляются при дифференцировке CD4+ Т лимфоцитов, когда они реагируют на действие антигена в периферических лимфатических тканях. Активированные макрофаги играют важную роль в разрушении опухолей путём образования фактора некроза опухоли альфа, гамма-интерферона, оксида азота, активных форм кислорода, катионных белков и гидролитических ферментов[75].
Нейтрофилы

Нейтрофилы обычно находятся в кровеносном русле и являются наиболее распространённым типом фагоцитов, составляя 50—60 % от всех циркулирующих в крови белых кровяных клеток[79]. Один литр крови взрослого человека в норме содержит около 2,5—7,5 миллиардов нейтрофилов[13]. Их диаметр составляет около 10 мкм[80], и живут нейтрофилы только в течение 5 дней[40]. Как только поступает соответствующий сигнал, они в течение примерно 30 минут выходят из крови и достигают зоны инфекции[81]. Они способны быстро поглощать чужеродный материал. Нейтрофилы не возвращаются в кровь, а превращаются в клетки гноя и погибают[81]. Зрелые нейтрофилы меньше, чем моноциты, и имеют сегментированные ядра с несколькими секциями; каждая секция соединяется с хроматиновыми нитями (нейтрофил может иметь 2—5 сегментов). Обычно нейтрофилы не выходят из костного мозга до наступления зрелости, но при инфекции высвобождаются в кровь предшественники нейтрофилов — миелоциты и промиелоциты[82].
Внутриклеточные гранулы нейтрофилов человека разрушают белки и обладают бактерицидными свойствами[83]. Нейтрофилы способны выделять вещества, которые стимулируют моноциты и макрофаги. Нейтрофильные выделения усиливают фагоцитоз и образование активных форм кислорода, участвуя таким образом во внутриклеточном уничтожении[84]. Выделения от первичных гранул нейтрофилов стимулируют фагоцитоз бактерий, покрытых IgG[85].
Дендритные клетки
Дендритные клетки — специализированные антиген-презентирующие клетки, у которых есть длинные отростки, называемые дендритами[86], которые помогают поглощать микробов и других патогенов[87][88]. Дендритные клетки находятся в тканях, которые контактируют с окружающей средой, в основном в коже, внутренней оболочке носа, лёгких, желудка и кишечника[89]. После активации они созревают и мигрируют в лимфатические ткани, где взаимодействуют с Т- и B-лимфоцитами для возникновения и организации приобретённого иммунного ответа[90].
Зрелые дендритные клетки активируют Т-хелперы и Т-киллеры[91]. Активированные Т-хелперы взаимодействуют с макрофагами и B-лимфоцитами, чтобы, в свою очередь, активировать их. Кроме того, дендритные клетки способны влиять на возникновение того или иного типа иммунного ответа; когда они перемещаются в лимфатические зоны, они способны активировать находящиеся там Т-лимфоциты, которые затем дифференцируют в Т-киллеры и Т-хелперы[92]
Тучные клетки
Тучные клетки имеют Toll-подобные рецепторы и взаимодействуют с дендритными клетками, Т- и B-лимфоцитами. Тучные клетки экспрессируют MHC класса II и могут принимать участие в презентации антигена; однако роль тучных клеток в презентации антигена ещё недостаточно изучена[93]. Тучные клетки способны поглощать, убивать грамотрицательные бактерии (например, сальмонеллу) и обрабатывать их антигены[94] Они специализируются на обработке фимбриальных белков на поверхности бактерий, которые участвуют в прикреплении к тканям[95][96]. Кроме этих функций, тучные клетки образуют цитокины, которые запускают реакцию воспаления[97]. Это важная часть уничтожения микробов, потому что цитокины привлекают больше фагоцитов к зоне инфекции[94].
Непрофессиональные фагоциты
Умирающие клетки и чужеродные организмы поглощаются клетками, отличными от «профессиональных» фагоцитов[98]. К таким клеткам относят эпителиальные, эндотелиальные, паренхиматозные клетки и фибробласты. Их называют непрофессиональными фагоцитами, чтобы подчеркнуть, что, в отличие от профессиональных фагоцитов, фагоцитоз для них не является основной функцией[99]. Фибробласты, например, которые могут фагоцитировать коллаген в процессе рассасывания рубцов, также способны частично поглощать чужеродные частицы[100].
Непрофессиональные фагоциты более ограничены, чем профессиональные, в отношении частиц, которые они могут поглотить. Это связано с отсутствием у них эффективных фагоцитарных рецепторов, в частности опсонинов[12]. Кроме того, большинство непрофессиональных фагоцитов не образуют реактивные кислород-содержащие молекулы для фагоцитоза[101].
| Основное расположение | Варианты фенотипов |
|---|---|
| Кровь, лимфа и лимфатические узлы | Лимфоциты |
| Кровь, лимфа и лимфатические узлы | Естественные киллеры и крупные гранулярные лимфоциты |
| Кожа | Эпителиоциты |
| Кровеносные сосуды | Эндотелиоциты |
| Соединительная ткань | Фибробласты |
| Кровь | Эритроциты |
Устойчивость патогена

Патоген вызывает инфекцию, если только он преодолел защитные рубежи организма. Патогенные бактерии и простейшие развивают различные механизмы устойчивости к атакам фагоцитов, и многие из них действительно выживают и размножаются внутри фагоцитирующих клеток[102][103].
Избежание контакта
У бактерий есть несколько способов избежать контакта с фагоцитами. Во-первых, они могут жить в местах, куда фагоциты не способны попасть (например, повреждённый кожный покров). Во-вторых, бактерия может подавлять реакцию воспаления; без воспаления фагоциты не способны реагировать на инфекцию адекватно. В-третьих, некоторые виды бактерий могут замедлять способность фагоцитов перемещаться в зону инфекции, препятствуя хемотаксису[102]. В-четвёртых, некоторые бактерии способны избегать контакта с фагоцитом путём обмана иммунной системы, которая начинает «думать», что бактерия — клетка самого макроорганизма. Бледная трепонема (бактерия, вызывающая сифилис) скрывается от фагоцитов, покрывая свою поверхность фибронектином[104], который естественно образуется в организме и играет важную роль в заживлении раны[105].
Избежание поглощения
Бактерии часто образуют белки или сахара, которые покрывают их клетки и препятствуют фагоцитозу; они входят в состав бактериальной капсулы[102]. Например, K5 капсульный антиген и O75 O-антиген присутствуют на поверхности Escherichia coli[106] и экзополисахаридных капсул Staphylococcus epidermidis[107]. Пневмококк образует несколько типов капсул, которые обеспечивают различные уровни защиты[108], а стрептококки группы А образуют белки, например M-белок и фимбриальные белки, которые блокируют процесс поглощения. Некоторые белки препятствуют опсонин-связанному поглощению; Staphylococcus aureus образует белок А для блокирования рецепторов антител, что снижает эффективность опсонинов[109].
Выживание внутри фагоцита

У бактерий развиты способы выживания внутри фагоцитов, где они продолжают уклоняться от иммунной системы[110]. Для безопасного проникновения внутрь фагоцита они выделяют белки, называемые «инвазинами». Оказавшись внутри клетки, они остаются в цитоплазме и избегают воздействия токсических веществ, содержащихся в фаголизосомах[111]. Некоторые бактерии препятствуют слиянию фагосомы и лизосомы[102]. Другие патогены, например лейшмании, образуют высокомодифицированные вакуоли внутри фагоцитов, что позволяет им сохранять устойчивость и размножаться[112]. Legionella pneumophila образует секрет, который заставляет фагоциты сливаться с везикулами, отличными от тех, что содержат токсичные вещества[113]. Другие бактерии способны жить внутри фаголизосом. Staphylococcus aureus, например, образует ферменты каталаза и супероксиддисмутаза, которые разрушают химические вещества (например, пероксид водорода), образуемые фагоцитами для уничтожения бактерий[114]. Бактерии могут выходить из фагосомы перед образованием фаголизосомы: Listeria monocytogenes способна образовывать отверстие в стенке фагосомы, используя ферменты, называемые листериолизин O и фосфолипаза C[115].
Уничтожение
У бактерий развиты некоторые способы уничтожения фагоцитов[109]. К ним относятся цитолизины, которые образуют поры в клеточной мембране фагоцитов, стрептолизины и лейкоцидины, которые вызывают разрыв гранул нейтрофилов, освобождение токсических веществ[116][117], и экзотоксины, которые снижают поступления АТФ для фагоцитов, необходимых для фагоцитоза. Будучи поглощёнными, бактерии могут убивать фагоциты, высвобождая токсины, которые перемещаются из мембран фагосом или фаголизосом к другим частям клетки[102].
Нарушение передачи сигнала в клетке
Некоторые стратегии выживания часто связаны с нарушением цитокиновой передачи и других методов передачи сигнала в клетке для предотвращения реакции фагоцитов на инвазию[118]. Такие паразитические простейшие, как, например, Toxoplasma gondii, Trypanosoma cruzi и Leishmania, инфицируют макрофаги; каждый из них имеет уникальный способ подавления активности макрофагов. Некоторые виды лейшманий изменяют систему сигналов инфицированных макрофагов, подавляют продукцию цитокинов и микробоцидных молекул (оксида азота, активных форм кислорода) и нарушают презентацию антигена[119].
Повреждение макроорганизма фагоцитами
Макрофаги и нейтрофилы, в частности, играют центральную роль в воспалительном процессе путём высвобождения белков и низкомолекулярных воспалительных медиаторов, которые контролируют инфекцию, но могут повреждать ткани макроорганизма. В общем, цель фагоцитов — разрушение патогенов путём поглощения их и последующего воздействия на них токсичными веществами внутри фаголизосом. Если фагоцит не в состоянии поглотить свою цель, эти токсические агенты могут быть выделены в окружающую среду (действие называется «фрустрированный фагоцитоз»). Так как эти агенты токсичны и для клеток макроорганизма, они могут вызвать значительное повреждение здоровых клеток и тканей[120].
Если нейтрофилы освобождают содержимое гранул (активные формы кислорода и протеазы) в почках, то происходит деградация внеклеточного матрикса организма, что может привести к повреждению клубочковых клеток, влияя на их способность фильтровать кровь и вызывая изменения в их форме. Кроме того, продукты фосфолипазы (например, лейкотриены) усиливают повреждение. Это освобождение веществ способствует хемотаксису большего количества нейтрофилов в зону инфекции, и клубочковые клетки могут быть повреждены ещё сильнее путём прикрепления молекул при миграции нейтрофилов. Повреждения клубочковых клеток может привести к почечной недостаточности[121].
Нейтрофилы также играют ключевую роль в развитии большинства форм острого повреждения лёгких[122]. При этом активированные нейтрофилы высвобождают содержимое своих токсичных гранул в лёгких[123]. Эксперименты показали, что уменьшение числа нейтрофилов снижает эффекты острого повреждения лёгких[124], но лечение подавлением нейтрофилов клинически не реалистично, так как при этом организм становится уязвим для инфекций[123]. В печени повреждение нейтрофилами может способствовать дисфункции и повреждению в ответ на освобождение эндотоксина, выделяемого бактерией, сепсис, травму, алкогольный гепатит, ишемию и гиповолемический шок в результате острой кровопотери[125].
Химические вещества, высвобождаемые макрофагами, могут также повреждать ткани организма. Фактор некроза опухоли-α (ФНО-α) — важное химическое вещество, выделяемое макрофагами, которое приводит к свёртыванию крови в мелких сосудах, что предотвращает распространение инфекции[126]. Однако, если бактериальная инфекция проникает в кровь, ФНО-α выделяется в жизненно важных органах, где может вызвать вазодилатацию и уменьшить объём плазмы; это, в свою очередь, может привести к септическому шоку. При септическом шоке высвобождение ФНО-α вызывает блокаду мелких сосудов, которые снабжают кровью жизненно важные органы, и может возникнуть их недостаточность. Септический шок может привести к смерти[14].
Эволюционное происхождение
Фагоцитоз, вероятно, появился на ранних этапах эволюции[127], впервые возникнув у одноклеточных эукариот[128]. Амёбы — одноклеточные простейшие, которые отделились от дерева, ведущего к многоклеточным, но они передали множество специфических функций фагоцитарным клеткам млекопитающих[128]. Слизевик Dictyostelium discoideum, например, живёт в почве и питается бактериями. Как и фагоциты животных, он поглощает бактерии путём фагоцитоза в основном с помощью Toll-подобных рецепторов[129]. Амёбы Dictyostelium discoideum социальны; они слипаются вместе, когда голодают, превращаясь в мигрирующий псевдоплазмодий. Такой многоклеточный организм в итоге образует плодовое тело со спорами, которое устойчиво к агрессии окружающей среды. Перед образованием плодовых тел клетки могут перемещаться как слизевики в течение нескольких дней. В течение этого времени воздействие токсинов или бактериальных патогенов может представлять опасность для выживания амёб, ограничивая образование спор. Некоторые амёбы поглощают бактерии и абсорбируют их токсины. В конечном итоге эти амёбы погибают. Они генетически схожи с другими амёбами в псевдоплазмодии и жертвуют собой для защиты других амёб от бактерий, что схоже с самопожертвованием фагоцитов иммунной системы человека. Такая врождённая иммунная функция у социальных амёб предполагает, что древний механизм поглощения клеток мог быть приспособлен для защитной функции задолго до появления разнообразных животных[130], но их общее происхождение с фагоцитами млекопитающих не доказано. Фагоциты присутствуют во всём животном царстве[4], начиная от морских губок и заканчивая насекомыми и позвоночными[131][132]. Способность амёб различать своих и чужих стала основой иммунной системы многих видов[8].
См. также
Примечания
- ↑ Little, C., Fowler H.W., Coulson J. The Shorter Oxford English Dictionary (англ.). — Oxford University Press (Guild Publishing), 1983. — P. 1566—1567.
- 1 2 Thompson C. B. Apoptosis in the pathogenesis and treatment of disease. (англ.) // Science (New York, N.Y.). — 1995. — Vol. 267, no. 5203. — P. 1456—1462. — PMID 7878464.
- 1 2 3 4 5 6 7 8 9 10 Gene Mayer. Immunology — Chapter One: Innate (non-specific) Immunity. Microbiology and Immunology On-Line Textbook. USC School of Medicine (2006). Дата обращения: 12 ноября 2008. Архивировано 23 августа 2011 года.
- 1 2 Delves, Martin, Burton, Roit, 2006, p. 250.
- ↑ Delves, Martin, Burton, Roit, 2006, p. 251.
- ↑ Ilya Mechnikov. Дата обращения: 12 сентября 2010. Архивировано 17 февраля 2015 года.
- 1 2 Schmalstieg F. C. Jr., Goldman A. S. Ilya Ilich Metchnikoff (1845-1915) and Paul Ehrlich (1854-1915): the centennial of the 1908 Nobel Prize in Physiology or Medicine. (англ.) // Journal of medical biography. — 2008. — Vol. 16, no. 2. — P. 96—103. — doi:10.1258/jmb.2008.008006. — PMID 18463079.
- 1 2 Janeway C. A. Jr. Evolution of the innate immune system. Дата обращения: 3 октября 2017. Архивировано 31 декабря 2022 года.
- 1 2 Ernst, Stendahl, 2006, p. 186.
- 1 2 Robinson, Babcock, 1998, p. 187.
- ↑ Ernst, Stendahl, 2006, p. 7—10.
- 1 2 Ernst, Stendahl, 2006, p. 10.
- 1 2 3 Hoffbrand, Pettit, Moss, 2005, p. 331.
- 1 2 3 Janeway C. A. Jr. Induced innate responses to infection. Дата обращения: 3 октября 2017. Архивировано 31 декабря 2022 года.
- 1 2 Fang F. C. Antimicrobial reactive oxygen and nitrogen species: concepts and controversies. (англ.) // Nature reviews. Microbiology. — 2004. — Vol. 2, no. 10. — P. 820—832. — doi:10.1038/nrmicro1004. — PMID 15378046.
- 1 2 Janeway C. A. Jr. Antigen Presentation to T Lymphocytes.
- ↑ Ambrose C. T. The Osler Slide, a Demonstration of Phagocytosis from 1876: Reports of Phagocytosis before Metchnikoff’s 1880 Paper // Cellular Immunology. — 2006. — Vol. 240, no. 1. — P. 1—4. — ISSN 0008-8749. — doi:10.1016/j.cellimm.2006.05.008.
- ↑ Fetal and Neonatal Physiology. 5th edition / Ed. by R. A. Polin, S. H. Abman, D. H. Rowitch, W. E. Benitz, W. W. Fox. — Philadelphia: Elsevier Health Sciences, 2016. — xxxvii + 2050 p. — ISBN 978-0-323-35214-7. Архивировано 31 декабря 2016 года. — P. 1221.
- ↑ Kaufmann S. H. E. Immunology’s foundation: the 100-year anniversary of the Nobel Prize to Paul Ehrlich and Elie Metchnikoff // Nature Immunology. — 2008. — Vol. 9, no. 7. — P. 705—712. — ISSN 1529-2908. — doi:10.1038/ni0708-705.
- ↑ Delves, Martin, Burton, Roit, 2006, p. 3.
- ↑ Aterman K. Medals, memoirs--and Metchnikoff. (англ.) // Journal of leukocyte biology. — 1998. — Vol. 63, no. 4. — P. 515—517. — PMID 9544583.
- ↑ Ilya Mechnikov. The Nobel Foundation. Дата обращения: 28 ноября 2008. Архивировано 10 февраля 2012 года.
- ↑ Delves, Martin, Burton, Roit, 2006, p. 263.
- ↑ Robinson, Babcock, 1998, p. vii.
- ↑ Ernst, Stendahl, 2006, p. 4.
- ↑ Ernst, Stendahl, 2006, p. 78.
- 1 2 Hampton M. B., Vissers M. C., Winterbourn C. C. A single assay for measuring the rates of phagocytosis and bacterial killing by neutrophils. (англ.) // Journal of leukocyte biology. — 1994. — Vol. 55, no. 2. — P. 147—152. — PMID 8301210.
- ↑ Delves, Martin, Burton, Roit, 2006, p. 6—7.
- ↑ Sompayrac, 2008, p. 3.
- ↑ Sompayrac, 2008, p. 13—16.
- ↑ Dale D. C., Boxer L., Liles W. C. The phagocytes: neutrophils and monocytes. (англ.) // Blood. — 2008. — Vol. 112, no. 4. — P. 935—945. — doi:10.1182/blood-2007-12-077917. — PMID 18684880.
- ↑ Dahlgren C., Karlsson A. Respiratory burst in human neutrophils. (англ.) // Journal of immunological methods. — 1999. — Vol. 232, no. 1-2. — P. 3—14. — PMID 10618505.
- ↑ Shatwell K. P., Segal A. W. NADPH oxidase. (англ.) // The international journal of biochemistry & cell biology. — 1996. — Vol. 28, no. 11. — P. 1191—1195. — PMID 9022278.
- ↑ Klebanoff S. J. Myeloperoxidase. (англ.) // Proceedings of the Association of American Physicians. — 1999. — Vol. 111, no. 5. — P. 383—389. — PMID 10519157.
- ↑ Meyer K. C. Neutrophils, myeloperoxidase, and bronchiectasis in cystic fibrosis: green is not good. (англ.) // The Journal of laboratory and clinical medicine. — 2004. — Vol. 144, no. 3. — P. 124—126. — PMID 15478278.
- ↑ Hoffbrand, Pettit, Moss, 2005, p. 118.
- ↑ Delves, Martin, Burton, Roit, 2006, p. 6—10.
- ↑ Schroder K., Hertzog P. J., Ravasi T., Hume D. A. Interferon-gamma: an overview of signals, mechanisms and functions. (англ.) // Journal of leukocyte biology. — 2004. — Vol. 75, no. 2. — P. 163—189. — doi:10.1189/jlb.0603252. — PMID 14525967.
- ↑ Delves, Martin, Burton, Roit, 2006, p. 188.
- 1 2 Sompayrac, 2008, p. 17.
- ↑ Tipu H. N., Ahmed T. A., Ali S., Ahmed D., Waqar M. A. Chronic granulomatous disease. (англ.) // JPMA. The Journal of the Pakistan Medical Association. — 2008. — Vol. 58, no. 9. — P. 516—518. — PMID 18846805.
- ↑ Kaplan J., De Domenico I., Ward D. M. Chediak-Higashi syndrome. (англ.) // Current opinion in hematology. — 2008. — Vol. 15, no. 1. — P. 22—29. — doi:10.1097/MOH.0b013e3282f2bcce. — PMID 18043242.
- ↑ Sompayrac, 2008, p. 7.
- ↑ de Almeida S. M., Nogueira M. B., Raboni S. M., Vidal L. R. Laboratorial diagnosis of lymphocytic meningitis. (англ.) // The Brazilian journal of infectious diseases : an official publication of the Brazilian Society of Infectious Diseases. — 2007. — Vol. 11, no. 5. — P. 489—495. — PMID 17962876.
- ↑ Sompayrac, 2008, p. 22.
- ↑ Sompayrac, 2008, p. 63.
- ↑ Apoptosis. Merriam-Webster Online Dictionary. Дата обращения: 19 марта 2009. Архивировано 10 февраля 2012 года.
- ↑ Li M. O., Sarkisian M. R., Mehal W. Z., Rakic P., Flavell R. A. Phosphatidylserine receptor is required for clearance of apoptotic cells. (англ.) // Science (New York, N.Y.). — 2003. — Vol. 302, no. 5650. — P. 1560—1563. — doi:10.1126/science.1087621. — PMID 14645847.
- ↑ Wang X., Wu Y. C., Fadok V. A., Lee M. C., Gengyo-Ando K., Cheng L. C., Ledwich D., Hsu P. K., Chen J. Y., Chou B. K., Henson P., Mitani S., Xue D. Cell corpse engulfment mediated by C. elegans phosphatidylserine receptor through CED-5 and CED-12. (англ.) // Science (New York, N.Y.). — 2003. — Vol. 302, no. 5650. — P. 1563—1566. — doi:10.1126/science.1087641. — PMID 14645848.
- ↑ Savill J., Gregory C., Haslett C. Cell biology. Eat me or die. (англ.) // Science (New York, N.Y.). — 2003. — Vol. 302, no. 5650. — P. 1516—1517. — doi:10.1126/science.1092533. — PMID 14645835.
- ↑ Zhou Z., Yu X. Phagosome maturation during the removal of apoptotic cells: receptors lead the way. (англ.) // Trends in cell biology. — 2008. — Vol. 18, no. 10. — P. 474—485. — doi:10.1016/j.tcb.2008.08.002. — PMID 18774293.
- ↑ Sompayrac, 2008, p. 44.
- ↑ Sompayrac, 2008, p. 4.
- ↑ Sompayrac, 2008, p. 24—35.
- ↑ Delves, Martin, Burton, Roit, 2006, pp. 171—184.
- ↑ Delves, Martin, Burton, Roit, 2006, p. 456.
- ↑ Timothy Lee. Antigen Presenting Cells (APC). Immunology for 1st Year Medical Students. Dalhousie University (2004). Дата обращения: 12 ноября 2008. Архивировано 12 января 2008 года.
- ↑ Delves, Martin, Burton, Roit, 2006, p. 161.
- ↑ Sompayrac, 2008, p. 8.
- ↑ Delves, Martin, Burton, Roit, 2006, p. 237—242.
- ↑ Lange C., Dürr M., Doster H., Melms A., Bischof F. Dendritic cell-regulatory T-cell interactions control self-directed immunity. (англ.) // Immunology and cell biology. — 2007. — Vol. 85, no. 8. — P. 575—581. — doi:10.1038/sj.icb.7100088. — PMID 17592494.
- 1 2 Steinman, Ralph M. Dendritic Cells and Immune Tolerance. The Rockefeller University (2004). Дата обращения: 15 февраля 2009. Архивировано из оригинала 11 марта 2009 года.
- ↑ Romagnani S. Immunological tolerance and autoimmunity. (англ.) // Internal and emergency medicine. — 2006. — Vol. 1, no. 3. — P. 187—196. — PMID 17120464.
- 1 2 Paoletti, Notario, Ricevuti, 1997, p. 427.
- ↑ Sompayrac, 2008, p. 16—17.
- ↑ Sompayrac, 2008, p. 18—19.
- ↑ Delves, Martin, Burton, Roit, 2006, p. 6.
- ↑ Zen K., Parkos C. A. Leukocyte-epithelial interactions. (англ.) // Current opinion in cell biology. — 2003. — Vol. 15, no. 5. — P. 557—564. — PMID 14519390.
- ↑ Sompayrac, 2008, p. 79.
- ↑ Hoffbrand, Pettit, Moss, 2005, p. 117.
- ↑ Delves, Martin, Burton, Roit, 2006, p. 1—6.
- ↑ Sompayrac, 2008, p. 45.
- ↑ Takahashi K., Naito M., Takeya M. Development and heterogeneity of macrophages and their related cells through their differentiation pathways. (англ.) // Pathology international. — 1996. — Vol. 46, no. 7. — P. 473—485. — PMID 8870002.
- ↑ Krombach F., Münzing S., Allmeling A. M., Gerlach J. T., Behr J., Dörger M. Cell size of alveolar macrophages: an interspecies comparison. (англ.) // Environmental health perspectives. — 1997. — Vol. 105 Suppl 5. — P. 1261—1263. — PMID 9400735.
- 1 2 3 4 Bowers William. Immunology -Chapter Thirteen: Immunoregulation. Microbiology and Immunology On-Line Textbook. USC School of Medicine (2006). Дата обращения: 14 ноября 2008. Архивировано 23 августа 2011 года.
- ↑ Ernst, Stendahl, 2006, p. 8.
- ↑ Delves, Martin, Burton, Roit, 2006, p. 156.
- ↑ Delves, Martin, Burton, Roit, 2006, p. 187.
- ↑ Stvrtinová Viera, Ján Jakubovský and Ivan Hulín. Neutrophils, central cells in acute inflammation // Inflammation and Fever from Pathophysiology: Principles of Disease (англ.). — Computing Centre, Slovak Academy of Sciences: Academic Electronic Press, 1995. — ISBN 80-967366-1-2. Архивировано 31 декабря 2010 года. Архивированная копия. Дата обращения: 19 сентября 2010. Архивировано из оригинала 31 декабря 2010 года.
- ↑ Delves, Martin, Burton, Roit, 2006, p. 4.
- 1 2 Sompayrac, 2008, p. 18.
- ↑ Linderkamp O., Ruef P., Brenner B., Gulbins E., Lang F. Passive deformability of mature, immature, and active neutrophils in healthy and septicemic neonates. (англ.) // Pediatric research. — 1998. — Vol. 44, no. 6. — P. 946—950. — doi:10.1203/00006450-199812000-00021. — PMID 9853933.
- ↑ Paoletti, Notario, Ricevuti, 1997, p. 62.
- ↑ Soehnlein O., Kenne E., Rotzius P., Eriksson E. E., Lindbom L. Neutrophil secretion products regulate anti-bacterial activity in monocytes and macrophages. (англ.) // Clinical and experimental immunology. — 2008. — Vol. 151, no. 1. — P. 139—145. — doi:10.1111/j.1365-2249.2007.03532.x. — PMID 17991288.
- ↑ Soehnlein O., Kai-Larsen Y., Frithiof R., Sorensen O. E., Kenne E., Scharffetter-Kochanek K., Eriksson E. E., Herwald H., Agerberth B., Lindbom L. Neutrophil primary granule proteins HBP and HNP1-3 boost bacterial phagocytosis by human and murine macrophages. (англ.) // The Journal of clinical investigation. — 2008. — Vol. 118, no. 10. — P. 3491—3502. — doi:10.1172/JCI35740. — PMID 18787642.
- ↑ Steinman R. M., Cohn Z. A. Identification of a novel cell type in peripheral lymphoid organs of mice. I. Morphology, quantitation, tissue distribution. (англ.) // The Journal of experimental medicine. — 1973. — Vol. 137, no. 5. — P. 1142—1162. — PMID 4573839.
- ↑ Steinman Ralph. Dendritic Cells. The Rockefeller University. Дата обращения: 14 ноября 2008. Архивировано 10 февраля 2012 года.
- ↑ Guermonprez P., Valladeau J., Zitvogel L., Théry C., Amigorena S. Antigen presentation and T cell stimulation by dendritic cells. (англ.) // Annual review of immunology. — 2002. — Vol. 20. — P. 621—667. — doi:10.1146/annurev.immunol.20.100301.064828. — PMID 11861614.
- ↑ Hoffbrand, Pettit, Moss, 2005, p. 134.
- ↑ Sallusto F., Lanzavecchia A. The instructive role of dendritic cells on T-cell responses. (англ.) // Arthritis research. — 2002. — Vol. 4 Suppl 3. — P. 127—132. — doi:10.1186/ar567. — PMID 12110131.
- ↑ Sompayrac, 2008, pp. 42—46.
- ↑ Steinman Ralph. Dendritic Cells. The Rockefeller University. Дата обращения: 16 ноября 2008. Архивировано 10 февраля 2012 года.
- ↑ Stelekati E., Orinska Z., Bulfone-Paus S. Mast cells in allergy: innate instructors of adaptive responses. (англ.) // Immunobiology. — 2007. — Vol. 212, no. 6. — P. 505—519. — doi:10.1016/j.imbio.2007.03.012. — PMID 17544835.
- 1 2 Malaviya R., Abraham S. N. Mast cell modulation of immune responses to bacteria. (англ.) // Immunological reviews. — 2001. — Vol. 179. — P. 16—24. — PMID 11292019.
- ↑ Connell I., Agace W., Klemm P., Schembri M., Mărild S., Svanborg C. Type 1 fimbrial expression enhances Escherichia coli virulence for the urinary tract. (англ.) // Proceedings of the National Academy of Sciences of the United States of America. — 1996. — Vol. 93, no. 18. — P. 9827—9832. — PMID 8790416.
- ↑ Malaviya R., Twesten N. J., Ross E. A., Abraham S. N., Pfeifer J. D. Mast cells process bacterial Ags through a phagocytic route for class I MHC presentation to T cells. (англ.) // Journal of immunology (Baltimore, Md. : 1950). — 1996. — Vol. 156, no. 4. — P. 1490—1496. — PMID 8568252.
- ↑ Taylor M. L., Metcalfe D. D. Mast cells in allergy and host defense. (англ.) // Allergy and asthma proceedings. — 2001. — Vol. 22, no. 3. — P. 115—119. — PMID 11424870.
- ↑ Birge R. B., Ucker D. S. Innate apoptotic immunity: the calming touch of death. (англ.) // Cell death and differentiation. — 2008. — Vol. 15, no. 7. — P. 1096—1102. — doi:10.1038/cdd.2008.58. — PMID 18451871.
- ↑ Couzinet S., Cejas E., Schittny J., Deplazes P., Weber R., Zimmerli S. Phagocytic uptake of Encephalitozoon cuniculi by nonprofessional phagocytes. (англ.) // Infection and immunity. — 2000. — Vol. 68, no. 12. — P. 6939—6945. — PMID 11083817.
- ↑ Segal G., Lee W., Arora P. D., McKee M., Downey G., McCulloch C. A. Involvement of actin filaments and integrins in the binding step in collagen phagocytosis by human fibroblasts. (англ.) // Journal of cell science. — 2001. — Vol. 114, no. Pt 1. — P. 119—129. — PMID 11112696.
- ↑ Rabinovitch M. Professional and non-professional phagocytes: an introduction. (англ.) // Trends in cell biology. — 1995. — Vol. 5, no. 3. — P. 85—87. — PMID 14732160.
- 1 2 3 4 5 Todar Kenneth. Mechanisms of Bacterial Pathogenicity: Bacterial Defense Against Phagocytes. 2008. Дата обращения: 10 декабря 2008. Архивировано 10 февраля 2012 года.
- ↑ Alexander J., Satoskar A. R., Russell D. G. Leishmania species: models of intracellular parasitism. (англ.) // Journal of cell science. — 1999. — Vol. 112 Pt 18. — P. 2993—3002. — PMID 10462516.
- ↑ Celli J., Finlay B. B. Bacterial avoidance of phagocytosis. (англ.) // Trends in microbiology. — 2002. — Vol. 10, no. 5. — P. 232—237. — PMID 11973157.
- ↑ Valenick L. V., Hsia H. C., Schwarzbauer J. E. Fibronectin fragmentation promotes alpha4beta1 integrin-mediated contraction of a fibrin-fibronectin provisional matrix. (англ.) // Experimental cell research. — 2005. — Vol. 309, no. 1. — P. 48—55. — doi:10.1016/j.yexcr.2005.05.024. — PMID 15992798.
- ↑ Burns S. M., Hull S. I. Loss of resistance to ingestion and phagocytic killing by O(-) and K(-) mutants of a uropathogenic Escherichia coli O75:K5 strain. (англ.) // Infection and immunity. — 1999. — Vol. 67, no. 8. — P. 3757—3762. — PMID 10417134.
- ↑ Vuong C., Kocianova S., Voyich J. M., Yao Y., Fischer E. R., DeLeo F. R., Otto M. A crucial role for exopolysaccharide modification in bacterial biofilm formation, immune evasion, and virulence. (англ.) // The Journal of biological chemistry. — 2004. — Vol. 279, no. 52. — P. 54881—54886. — doi:10.1074/jbc.M411374200. — PMID 15501828.
- ↑ Melin M., Jarva H., Siira L., Meri S., Käyhty H., Väkeväinen M. Streptococcus pneumoniae capsular serotype 19F is more resistant to C3 deposition and less sensitive to opsonophagocytosis than serotype 6B. (англ.) // Infection and immunity. — 2009. — Vol. 77, no. 2. — P. 676—684. — doi:10.1128/IAI.01186-08. — PMID 19047408.
- 1 2 Foster T. J. Immune evasion by staphylococci. (англ.) // Nature reviews. Microbiology. — 2005. — Vol. 3, no. 12. — P. 948—958. — doi:10.1038/nrmicro1289. — PMID 16322743.
- ↑ Sansonetti P. Phagocytosis of bacterial pathogens: implications in the host response. (англ.) // Seminars in immunology. — 2001. — Vol. 13, no. 6. — P. 381—390. — doi:10.1006/smim.2001.0335. — PMID 11708894.
- ↑ Dersch P., Isberg R. R. A region of the Yersinia pseudotuberculosis invasin protein enhances integrin-mediated uptake into mammalian cells and promotes self-association. (англ.) // The EMBO journal. — 1999. — Vol. 18, no. 5. — P. 1199—1213. — doi:10.1093/emboj/18.5.1199. — PMID 10064587.
- ↑ Antoine J. C., Prina E., Lang T., Courret N. The biogenesis and properties of the parasitophorous vacuoles that harbour Leishmania in murine macrophages. (англ.) // Trends in microbiology. — 1998. — Vol. 6, no. 10. — P. 392—401. — PMID 9807783.
- ↑ Masek Katherine S., Christopher A. Hunter. Eurekah Bioscience Collection: Evasion of Phagosome Lysosome Fusion and Establishment of a Replicative Organelle by the Intracellular Pathogen Legionella pneumophila (англ.). — Landes Bioscience, 2007.
- ↑ Das D., Saha S. S., Bishayi B. Intracellular survival of Staphylococcus aureus: correlating production of catalase and superoxide dismutase with levels of inflammatory cytokines. (англ.) // Inflammation research : official journal of the European Histamine Research Society ... [et al.]. — 2008. — Vol. 57, no. 7. — P. 340—349. — doi:10.1007/s00011-007-7206-z. — PMID 18607538.
- ↑ Hara H., Kawamura I., Nomura T., Tominaga T., Tsuchiya K., Mitsuyama M. Cytolysin-dependent escape of the bacterium from the phagosome is required but not sufficient for induction of the Th1 immune response against Listeria monocytogenes infection: distinct role of Listeriolysin O determined by cytolysin gene replacement. (англ.) // Infection and immunity. — 2007. — Vol. 75, no. 8. — P. 3791—3801. — doi:10.1128/IAI.01779-06. — PMID 17517863.
- ↑ Datta V., Myskowski S. M., Kwinn L. A., Chiem D. N., Varki N., Kansal R. G., Kotb M., Nizet V. Mutational analysis of the group A streptococcal operon encoding streptolysin S and its virulence role in invasive infection. (англ.) // Molecular microbiology. — 2005. — Vol. 56, no. 3. — P. 681—695. — doi:10.1111/j.1365-2958.2005.04583.x. — PMID 15819624.
- ↑ Iwatsuki K., Yamasaki O., Morizane S., Oono T. Staphylococcal cutaneous infections: invasion, evasion and aggression. (англ.) // Journal of dermatological science. — 2006. — Vol. 42, no. 3. — P. 203—214. — doi:10.1016/j.jdermsci.2006.03.011. — PMID 16679003.
- ↑ Denkers E. Y., Butcher B. A. Sabotage and exploitation in macrophages parasitized by intracellular protozoans. (англ.) // Trends in parasitology. — 2005. — Vol. 21, no. 1. — P. 35—41. — doi:10.1016/j.pt.2004.10.004. — PMID 15639739.
- ↑ Gregory D. J., Olivier M. Subversion of host cell signalling by the protozoan parasite Leishmania. (англ.) // Parasitology. — 2005. — Vol. 130 Suppl. — P. 27—35. — doi:10.1017/S0031182005008139. — PMID 16281989.
- ↑ Paoletti, Notario, Ricevuti, 1997, p. 426—430.
- ↑ Heinzelmann M., Mercer-Jones M. A., Passmore J. C. Neutrophils and renal failure. (англ.) // American journal of kidney diseases : the official journal of the National Kidney Foundation. — 1999. — Vol. 34, no. 2. — P. 384—399. — doi:10.1053/AJKD03400384. — PMID 10430993.
- ↑ Lee W. L., Downey G. P. Neutrophil activation and acute lung injury. (англ.) // Current opinion in critical care. — 2001. — Vol. 7, no. 1. — P. 1—7. — PMID 11373504.
- 1 2 Moraes T. J., Zurawska J. H., Downey G. P. Neutrophil granule contents in the pathogenesis of lung injury. (англ.) // Current opinion in hematology. — 2006. — Vol. 13, no. 1. — P. 21—27. — PMID 16319683.
- ↑ Abraham E. Neutrophils and acute lung injury. (англ.) // Critical care medicine. — 2003. — Vol. 31, no. 4 Suppl. — P. 195—199. — doi:10.1097/01.CCM.0000057843.47705.E8. — PMID 12682440.
- ↑ Ricevuti G. Host tissue damage by phagocytes. (англ.) // Annals of the New York Academy of Sciences. — 1997. — Vol. 832. — P. 426—448. — PMID 9704069.
- ↑ Charley B., Riffault S., Van Reeth K. Porcine innate and adaptative immune responses to influenza and coronavirus infections. (англ.) // Annals of the New York Academy of Sciences. — 2006. — Vol. 1081. — P. 130—136. — doi:10.1196/annals.1373.014. — PMID 17135502.
- ↑ Sompayrac, 2008, p. 1.
- 1 2 Cosson P., Soldati T. Eat, kill or die: when amoeba meets bacteria. (англ.) // Current opinion in microbiology. — 2008. — Vol. 11, no. 3. — P. 271—276. — doi:10.1016/j.mib.2008.05.005. — PMID 18550419.
- ↑ Bozzaro S., Bucci C., Steinert M. Phagocytosis and host-pathogen interactions in Dictyostelium with a look at macrophages. (англ.) // International review of cell and molecular biology. — 2008. — Vol. 271. — P. 253—300. — doi:10.1016/S1937-6448(08)01206-9. — PMID 19081545.
- ↑ Chen G., Zhuchenko O., Kuspa A. Immune-like phagocyte activity in the social amoeba. (англ.) // Science (New York, N.Y.). — 2007. — Vol. 317, no. 5838. — P. 678—681. — doi:10.1126/science.1143991. — PMID 17673666.
- ↑ Delves, Martin, Burton, Roit, 2006, pp. 251—252.
- ↑ Hanington P. C., Tam J., Katzenback B. A., Hitchen S. J., Barreda D. R., Belosevic M. Development of macrophages of cyprinid fish. (англ.) // Developmental and comparative immunology. — 2009. — Vol. 33, no. 4. — P. 411—429. — doi:10.1016/j.dci.2008.11.004. — PMID 19063916.
Литература
- Delves P. J., Martin S. J., Burton D. R., Roit I. M. Roitt's Essential Immunology. — 11th edition. — Malden, MA: Blackwell Publishing, 2006. — ISBN 1405136030.
- Phagocytosis of Bacteria and Bacterial Pathogenicity / Ernst J. D., Stendahl O. — New York: Cambridge University Press, 2006. — ISBN 0521845696.
- Hoffbrand A. V., Pettit J. E., Moss P. A. H. Essential Haematology. — 4th edition. — London: Blackwell Science, 2005. — ISBN 0632051531.
- Janeway C. A., Murphy K. M., Travers P., Walport M. Immunobiology. — 5th edition. — New York: Garland Science, 2001. — ISBN 081533642X.
- Phagocytes: Biology, Physiology, Pathology, and Pharmacotherapeutics / Paoletti R., Notario A., Ricevuti G. — New York: The New York Academy of Sciences, 1997. — ISBN 1573311022.
- Phagocyte Function — A guide for research and clinical evaluation / Robinson J. P., Babcock G. F. — New York: Wiley–Liss, 1998. — ISBN 0471123641.
- Sompayrac L. How the Immune System Works. — 3rd edition. — Malden, MA: Blackwell Publishing, 2008. — ISBN 9781405162210.